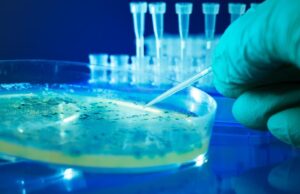
Επιστήμονες δημιούργησαν τους πρώτους ιούς που σχεδιάστηκαν από τεχνητή νοημοσύνη

admin-b
Τι πρέπει να γνωρίζουν οι έγκυες για την παρακεταμόλη
Ο Ντόναλντ Τραμπ προκάλεσε σάλο με τις τελευταίες δηλώσεις του στον Λευκό Οίκο, καλώντας τις εγκύους να αποφύγουν πλήρως τη χρήση παρακεταμόλης (Tylenol) και...
Καρχαρίες καταγράφονται σε ερωτικό τρίο για πρώτη φορά (βίντεο)
Ερευνητές που παρατηρούσαν καρχαρίες ενός απειλούμενου είδους ανοιχτά της Νέας Καληδονίας είχαν μια απρόσμενη έκπληξη όταν έγιναν μάρτυρες του πρώτου καταγεγραμμένου «τρίο» καρχαριών στον...
Άγνωστο μυστηριώδες είδος αρχαίων άστρων ανακαλύφθηκε στο γαλαξία μας
Νέες προσομοιώσεις υποδεικνύουν ότι τα σφαιρωτά σμήνη σχηματίζονται με πολλούς τρόπους και δείχνουν ένα μυστηριώδες νέο είδος αστρικού συστήματος που ίσως ήδη κρύβεται στο...
Επιστήμονες δημιούργησαν τους πρώτους ιούς που σχεδιάστηκαν από τεχνητή νοημοσύνη
Ερευνητική ομάδα χρησιμοποίησε τεχνητή νοημοσύνη για να δημιουργήσει συνεκτικά ιογενή γονιδιώματα και στη συνέχεια τα χρησιμοποίησε για να συνθέσει βακτηριοφάγους ικανούς να σκοτώσουν ανθεκτικά...
Η NASA μελετά δημιουργία διαδικτύου στην Σελήνη
Οι μηχανικοί της NASA μελετούν τρόπους ούτως ώστε οι μελλοντικοί αστροναύτες στη Σελήνη να μπορούν να παραμένουν συνδεδεμένοι κατά τη διάρκεια των διαστημικών περιπάτων...
Σχολικές εργασίες στο σπίτι στην εποχή της AI: Μάθηση ή απλή...
Η σχολική εργασία για το σπίτι υπήρξε πάντα ένα βασικό στοιχείο της διδασκαλίας και της μάθησης. Θεωρείται συνήθως ως εργαλείο για την εδραίωση της...
Τα βακτήρια του εντέρου ίσως προβλέπουν τον πρόωρο τοκετό, δείχνει νέα...
Κι αν τα βακτήρια του εντέρου σου μπορούσαν να προβλέψουν τον πρόωρο τοκετό; Μια νέα μελέτη δείχνει ότι αυτό είναι δυνατό!
Μια πρωτοποριακή μελέτη υποστηρίζει...
Γ. Δανός: Σημαντική στιγμή στις έρευνες για ανακάλυψη ζωής στον Άρη...
Σημαντική στιγμή στην έρευνα για ανακάλυψη ζωής στον κόκκινο πλανήτη χαρακτήρισε ο Πρόεδρος του Κυπριακού Οργανισμού Εξερεύνησης Διαστήματος, Γιώργος Δανός, τη χθεσινή ανακοίνωση της NASA ότι...
Οι δασικές πυρκαγιές επιδεινώνουν την ποιότητα του αέρα σε απόσταση χιλιάδων...
Οι δασικές πυρκαγιές προκαλούν ένα «τοξικό μίγμα» ρύπων το οποίο μπορεί να επιδεινώσει την ποιότητα του αέρα χιλιάδες χιλιόμετρα μακριά από την εστία, ανακοίνωσε...
Ολική έκλειψη Σελήνης την Κυριακή – Ορατό το «Ματωμένο Φεγγάρι» από...
Την Κυριακή 7 Σεπτεμβρίου, ο ουρανός της Κύπρου θα χαρίσει ένα σπάνιο και εντυπωσιακό θέαμα: την ολική έκλειψη της Σελήνης, γνωστή και ως «Ματωμένο...